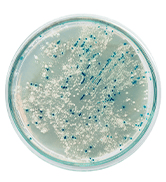
Time of Mold Exposure

Mold Symptoms

Is Your Home Making You Sick?
Biocide Labs now is now offering medical testing for mold exposure through our partnership with MLG medical. If you’re sick from mold, we have the medical answers you need.
Mold Exposure Symptoms
After an environment suffers from water intrusion, it becomes susceptible to mold growth. There are more than 100,000 potential species of mold that can contaminate your environment, many can be classified as toxic black mold. Even when the mold is not outright toxic, exposure to these species will ultimately take a toll on an individual’s health, leading to potential short-term and long-term mold exposure symptoms. We’ve compiled a list of these mold exposure symptoms and divided them into levels ranging from minor to severe, in order to help you determine the extent of your problem and decide if it’s time to begin the mold removal process.
Level I.
- Early Exposure to Mold
- Headaches
- Eye Irritation
- Sneezing
- Itching
- Skin Redness
- Skin Rash
Level II.
- Advanced Exposure to Mold
- Breathing Disorders
- Nose Bleeds
- Ear Infections
- Chronic Sinusitis
- Chronic Bronchitis
- Pain in the Muscles and Joints
- Asthma
- Nausea
- Vomiting
- Diarrhea
- Coughing up Blood or Black Debris
- Neurological Disorders
- Nervous Disorders
- Heart Palpitations
- Blurred Vision
- Swollen Glands
- Weight Loss
- Chronic Fatigue
- Loss of Appetite
- Depression
- Open Skin Sores or Lesions
- Fungal Nails (Hands or Feet)
- Sexual Dysfunction
- Thyroid Conditions
Level III.
- Long-Term Exposure to Mold
- Blindness
- COPD
- Hypersensitivity Pneumonitis
- Histoplasmosis
- Memory Loss (long-term)
- Bleeding Lungs
- Kidney Failure
- Liver Disease
- Cancer
- Death
Misdiagnosed?
The effects caused by mold exposure are often misdiagnosed; here are some common misdiagnoses:
- Fibromyalgia
- Rheumatoid Arthritis
- Inflammation
- Lupus
- Histoplasmosis
- COPD
- Lyme Disease
- Hypersensitivity Pneumonitis
Mold Symptoms
In addition to the list of mold symptoms, Mold has been classified as a carcinogenic (cancer-causing) substance by both the Centers for Disease Control and Prevention (CDC) and Environmental Protection Agency (EPA). However, the effects can differ from person to person, contingent on the 4 factors elaborated below:

Mold Spore Levels
Mold-allergy symptoms can be intensified by a high concentration of mold spores, even non-prolonged exposure can induce severe symptoms when the amount present is above a certain range. This elevated spore count is determined by an inspector when the indoor mold-spore levels are higher than those naturally present outside.
Time of Mold Exposure
As shown by the chart mold symptoms severity can increase over time. Mold particulates have the capability to build up in the human body. The longer you live in a mold-contaminated environment, the higher mold exposure risk factors become.

Mold Toxins
Species of mold, like Stachybotrys (black mold), are capable of emitting dangerous substances known as mycotoxins, they are the reason mold is classified as a carcinogen by both the CDC and the EPA.

Immune System
Everyone’s reaction to mold exposure will be different due to the capabilities of their immune systems to fight off environmental pathogens. However, whether your immune system provides strong or weak protection against mold’s effects, environmental pathogens will wear down the immune system over time.
The Next Step
We can help identify possible mold exposure from mold allergy symptoms to mycotoxin poisoning with this helpful tool. Learn if you or your family are exhibiting signs of mold sickness.
How can you confirm if mold is the reason you are sick?
In order to accurately ensure that there’s a connection between your environment and the symptoms you’re experiencing, you can take a variety of medical tests. Mycotoxin testing, DNA testing, Scratch Allergy testing, IgE (Immunoglobulin E) testing, and GI (Gastrointestinal) testing are all available for the purpose of clarifying whether or not you’re suffering from mold sickness. Having environmental tests conducted in addition to these medical tests is also recommended, as the data collected from each side of the overall question, and the resulting comparisons made, will provide you with the most precise answer.
Additionally, you can take our Online Health Screen.
What are some of the long-term effects of being exposed to mold?
After an individual is exposed to mold contaminants for an extended period, they may develop serious health complications, including but not limited to fungal infections, severe breathing disorders, mycotoxicosis, and neurological disorders.
How quickly can you develop mold sickness?
Ultimately, a person’s immune system determines how quickly they begin to succumb to mold exposure and develop symptoms. However, because mold has been known to result in allergic reactions, invasive fungal infections, and mycotoxin poisoning, the rate at which you could contract mold sickness is just one of the variables to keep in mind.
Can mold kill you?
Overexposure to environmental mold, mycotoxins, endotoxins, and bacteria have the potential to cause life-threatening ailments. The CDC classifies many environmental pathogens as carcinogens (cancer-causing).



